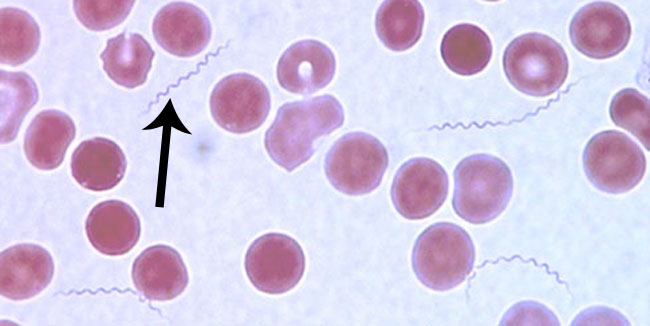
dur powrotny

Dur powrotny – przyczyny, objawy, leczenie
Dur powrotny to nawracająca choroba gorączkowa przenoszona przez wszy lub kleszcze. Istnieją dwa rodzaje nawracającej gorączki: nawracająca gorączka nawrotowa (TBRF); Wirusowa gorączka nawrotowa (LBRF).Objawy to powtarzające się epizody gorączkowe z bólami głowy, mięśniami i wymiotami trwającymi od 3 do 5 dni, oddzielone okresami pozornego powrotu do zdrowia. Rozpoznanie jest kliniczne, potwierdzone przez zabarwienie rozmazów krwi obwodowej. Leczenie odbywa się z pomocą tetracykliny lub erytromycyny.
Czym jest dur powrotny?
Choroba jest wywoływana przez krętki z rodzaju Borrelia. Przenoszona jest przez wszy odzieżowe lub klesze w zależności od położenia geograficznego. Dur powrotny pojawia się w regionach dotkniętych wojną, a także w obszarach najbardziej rozwijającymi się zmianami klimatycznymi. Zainfekowane wszy nie stanowią zagrożenia, dopóki nie zostaną zmiażdżone na swoim nosicielu Wtedy Borrelia zostaje wypuszczona i może wejść w skórę przez pory lub rany. W przypadku kleszy nie ma znaczenia naruszenie pasożyta – samo ugryzienie może spowodować powstanie choroby.
Rozmaz krwi obwodowej. Bakterie duru powrotnego ( krętki ) są długie i mają kształt spirali.
Okrągłe obiekty to czerwone krwinki.
Liczba przypadków śmiertelnych na ogół wynosi mniej niż 5% w przypadku leczenia, ale może być znacznie wyższa u osób bardzo młodych, starych, niedożywionych, osłabionych, a także u kobiet w ciąży. Bez stosowania odpowiednich leków śmiertelność wzrasta aż do 40%.
Objawy duru powrotnego
Bakterie są przenoszone przez ukąszenia gatunków miękkich kleszczy Ornithodoros. Te pasożyty żywią się głównie w nocy, a ich ugryzienie jest zwykle bezbolesne. Karmienie trwa tylko przez 15 do 30 minut, a następnie kleszcz odpada od skóry. To sprawia, że trudno jest wykryć go na ciele i zauważyć, że mogło dojść do zakażenia. W przypadku wszy występuje swędzenie, a rozduszenie pozostawia ślad, więc o wiele łatwiej o interwencję. Okres inkubacji choroby wynosi od 3 do 11 dni.
Do najczęstszych objawów duru powrotnego zalicza się:
-
dreszcze,
-
gorączkę,
-
bóle stawów,
-
bóle mięśni,
-
bóle głowy,
-
krwotoki podskórne,
-
epizodyczna wysoka gorączka,
-
żółtaczka,
-
powiększenie wątroby,
-
splenomegalia,
-
zapalenie mięśnia sercowego i niewydolność serca (szczególnie w chorobie wywołanej przez wszy).
Inne objawy mogą obejmować zapalenie gałki ocznej, tęczówki, zaostrzenie astmy i rumień wielopostaciowy. Mogą wystąpić powikłania neurologiczne (np. zapalenie opon mózgowo-rdzeniowych, zapalenie opon mózgowo-rdzeniowych, zapalenie rdzenia kręgowego), które są bardziej powszechne w durze powrotnym kleszczowym.
Objawy duru powrotnego mają tendencję do rozwoju w ciągu 7 dni po ukąszeniu kleszcza i utrzymują się średnio przez 3 dni (zakres 3-7 dni), po czym następują okres bezobjawowy przez 4-14 dni. Dolegliwości nawracają średnio 3 razy, ale wśród nieleczonych pacjentów może być to nawet do 10 razy. Epizody stają się stopniowo mniej poważne, a pacjenci ostatecznie wracają do zdrowia, gdy rozwijają odporność.
Czytaj również: Neuroborelioza, a Sm
Diagnoza duru powrotnego
Rozpoznanie duru powrotnego jest sugerowane przez nawracającą gorączkę i musi zostać potwierdzone przez wizualizację krętków we krwi podczas epizodu gorączkowego. Krętki mogą być widoczne na ciemnoniebieskim badaniu, czasem stosuje się także barwienia Wrighta lub Giemsy. Testy serologiczne, skuteczne w przypadku boreliozy lub kiły, są niewiarygodne, gdyż mogą być fałszywie pozytywne.
Leczenie duru powrotnego
W przypadku duru powrotnego przenoszonego przez kleszcze, leczenie obejmuje podawanie tetracykliny lub erytromycyny przez 5 do 10 dni. Zakażenie przez rozduszenie wszy jest łatwiejsze do opanowania i tu skuteczna jest pojedyncza dawka 500 mg obu specyfików dostarczana doustnie. Gdy wymioty lub ciężka choroba uniemożliwiają podawanie leków, chorzy są hospitalizowani i otrzymują medykamenty w mniejszych stężeniach przez kroplówkę.
Terapię należy rozpocząć wcześnie podczas gorączki. Reakcja Jarisch-Herxheimera (pojawiająca się wtedy, gdy z zabitych krętów uwalnia się toksyna) może wystąpić w ciągu 2 godzin od rozpoczęcia leczenia. Niedogodności można zmniejszyć przez podanie acetaminofenu.
Odwodnienie i zaburzenie równowagi elektrolitowej należy skorygować za pomocą płynów pozajelitowych. Acetaminofen z oksykodonem lub hydrokodonem powinien być stosowany w przypadku silnego bólu głowy. Nudności i wymioty należy leczyć prochlorperazyną w dawce od 5 do 10 mg.
Zobacz także inne choroby i tematy związane z kleszczami:
Profilaktyka antykleszczowa
Polega na zapobieganiu ukąszeniom przez kleszcze,unikaniu pobytu na terenach zwiększonego ryzyka, gdzie kleszcze występują często. Ochrona przed kleszczami zakłada jednak przede wszystkim właściwe ubieranie się na wyprawy do lasu czy na gęsto porośniętą łąkę. A to oznacza ubranie koszuli z długimi rękawami, spodni z długimi nogawkami, skarpetek i pełnych butów. Osłonić warto też głowę i szyję.Warto przy tym dodać, że najlepiej, jeśli jest to odzież w jasnych kolorach; na czarnej czarnego kleszcza nie zobaczymy. Należy stosować skuteczne środki na kleszcze, najlepiej zawierające DEET , które należy rozpylać na ubranie i odsłoniętą skórę, z wyjątkiem twarzy. Po każdym powrocie z terenów występowania kleszczy obowiązuje prysznic i dokładna kontrola całej skóry, zwłaszcza pachwin, pach, okolic za małżowinami usznymi i fałdów skórnych.
Do najsilniejszych repelentów na rynku należy preparat na kleszcze Mugga.

Uwaga!
- Powyższa porada jest jedynie sugestią i spisem informacji z wielu renomowanych źródeł i w przypadku problemów zdrowotnych nie może zastąpić wizyty u specjalisty. Zawsze w przypadku problemów ze zdrowiem należy bezwzględnie skonsultować się z lekarzem !
- Informacje opierają się na stanie wiedzy z dnia publikacji 13.07.2018 i mogą ulec zmianie.



